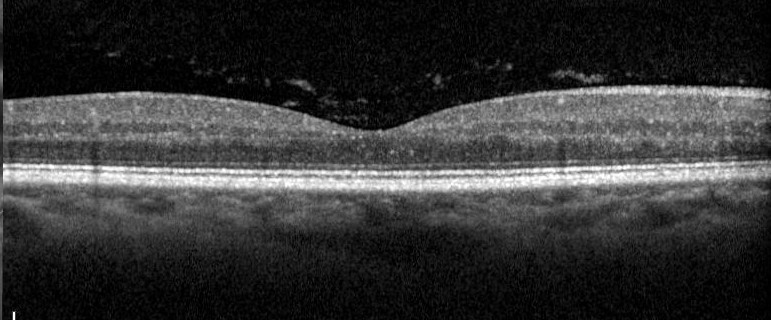
Vitreous condensation (opacities, floaters) Source: Mohammad Rafieetary, OD

Cataract: Strike!
Fall 2024
by Liz Hillman
Editorial Co-Director
According to one survey, 76% of a population (age 29.5ยฑ10.7 years) experience visual symptoms attributed to floaters.1
These wispy veils/curtains, cobweb-like threads, or thick diffuse clouds (three ways that Dagny Zhu, MD, describes different categories of vitreous opacities) can impact patient perception and happiness with their vision after cataract surgery.
While there are treatment options for floaters, there is some division as to methods of treatment, especially as YAG laser vitreolysis is becoming more common. Regardless, all of the physicians who spoke with EyeWorld on the topicโDr. Zhu as a cataract surgeon, and Christina Y. Weng, MD, MBA, and Steve Charles, MD, as retina specialistsโsaid they advise patients complaining of floaters to wait at least 6 months before pursuing treatment.
โI say [to patients]: โThese floaters will get less obvious with time.โ Then I say, โI didnโt say they would go away. โฆ I mean it when I say theyโll get less obvious with time, but if you look at a blue sky or a white sheet of paper, youโll still see them. If you look at a blank computer screen, youโll still see them,โโ Dr. Charles said, adding that he tells patients that he also has floaters, but he still performs complex medical procedures and flies jets. โI try to put the perspective that way.โ

Source: Dagny Zhu, MD

Source: Dagny Zhu, MD
Whatโs the impact?
Dr. Weng said that floaters can be โextremely bothersomeโ to patients, but she added, โI think we are often too dismissive of the symptoms they cause.โ
โMany patients have come to me after their cataract surgery unhappy with their surgical outcome even if they were 20/15 uncorrected,โ she said. โThere was one study that found that patients younger than 55 years of age were willing to accept a 7% risk of blindness to remove floaters.2 That statistic never ceases to shock me, but it emphasizes what a negative impact floaters can have on oneโs quality of life.
โConsidering how floaters can lead to postoperative dissatisfaction is increasingly important in the era of premium IOL technology where patients have higher expectations than ever before,โ Dr. Weng continued.
Dr. Zhu said that floaters should be on a surgeonโs workup for the 20/20-unhappy multifocal IOL patient. โPreviously when a multifocal patient was unhappy postop โฆ the most common reasons were refractive error, dry eye, or you blame the lens itself, and you recommend an IOL exchange. So many of those are now being diagnosed as floaters,โ Dr. Zhu said. โWeโve been neglecting the vitreous, which makes up more than 90% of the eye.โ
How to diagnose?
Dr. Zhu said patients will complain of blurry vision that comes and goes. She said she takes this discussion a step further, describing different symptoms that are more indicative of floaters, rather than something like a tear film disturbance.
โI ask them, โDo you notice a cloud or film that floats in front of your eye that comes and goes, especially as you move your eyes around?โ Then they say, โYes.โ They need your help in describing what they feel,โ she said.
Objectively, floaters can be observed on a slit lamp exam. Dr. Zhu said to create a thin, high-intensity beam, hold it at an angle, and focus on the anterior vitreous just behind the lens. If the floaters are deeper in the vitreous cavity, they can be viewed with a mid-vitreous lens. Sometimes they are also visible as a clump or Weiss ring floating over the retina on the dilated fundus exam with a 20 D lens. They can also be reviewed with an OCT macula en face view, represented as a gray or black shadow over the central retina.

Source: Christina Y. Weng, MD, MBA
Why the wait to treat?
As Dr. Charles said, patients who experience floaters after cataract surgery will notice them less over time. Why? Three reasons, he said. 1) Floaters will come further forward in the eye and out of the focal plane over time. 2) Theyโre slightly denser than liquid vitreous, so theyโll sink out of the visual axis. 3) The โmagicโ of 3D depth perception in the brain. As Dr. Charles put it, if something is only in one eye, there are about 15 decibels of suppression in that eye.
Dr. Weng also discussed neuroadaptation as a reason to wait on treating. She said with reassurance that there are treatment options should their symptoms persist or get worse, she has found most of her patients complaining of floaters donโt require further intervention.
Source: Mohammad Rafieetary, OD
How to treat?
Dr. Zhu said she only treats patients who are โimmensely symptomatic,โ who have waited 6 months after cataract surgery, and in whom she has eliminated all other possible causes, identifying floaters as the main culprit. Numerous studies show the impact of vitreous floaters on contrast sensitivity can be significant.
She tries to dissuade patients from surgical intervention at first, making sure they are truly bothered and donโt see any other option to improve their function or quality of life.
Dr. Zhu said she has been performing YAG vitreolysis in pseudophakic eyes for 3 years. She noted that there is one laser that is specifically approved for floaters (Ultra Q Reflex, Ellex), but she doesnโt have this one. Dr. Zhu said you want to go up a little on your power settings (3-5 mJ) and offset it posteriorly to avoid hitting the lens. โYou want to use a mid-vitreous lens so you can see exactly where you are. You donโt want to hit the retina, which is very unlikely if you stay in the mid-vitreous,โ she said. For dense cases, she will do several hundred spots, sometimes over a few sessions. Post โfloaterectomy,โ she puts the patient on a steroid for a week 4 times a day and might use dorzolamide/timolol in cases where the treatment is longer to mitigate any transient IOP spike. She said she has never had a retina issue with this treatment.
โI presented a case series at the ASCRS Annual Meeting3 where approximately 70% of my patients (n=77 eyes) noticed significant improvement after just a single YAG laser vitreolysis session. In their mind, subjectively, itโs helping, and theyโll often request an additional session,โ she said. She is currently performing additional studies evaluating contrast sensitivity pre- and post-YAG laser treatment.
By starting with YAG laser vitreolysis, Dr. Zhu said she is able to offer unhappy post-cataract patients a safe, effective, and less invasive treatment option compared to pars plana vitrectomy. If patients donโt see an improvement with YAG or have particularly dense opacities, she refers the patients for vitrectomy, which almost always resolves the issue. However, her vitrectomy referrals have decreased significantly since refining her YAG laser technique.
Dr. Charles said he thinks there is โa lot of hypeโ regarding YAG laser vitreolysis, but he considers it to have โa very modest benefit in phakic eyes.โ He also noted that some retinas and lenses have been hit by good surgeons, โso Iโm not a fan of YAG laser vitreolysis, and I donโt do it.โ
If a patientโs bothersome symptoms persist, he will perform a vitrectomy and only if they have had a prior posterior vitreous detachment.
Dr. Weng offered a similar perspective. She said if the patientโs symptoms persist after the waiting period, she has an in-depth discussion with them about pars plana vitrectomy.
โWhile YAG vitreolysis is being offered by some as an alternative treatment option, I do not yet think that we fully understand the nuances of this procedure in this context; there has only been one randomized controlled trial of YAG vitreolysis for floaters to date,โ4 she said, noting questions about optimal energy settings, number of spots, where to aim, and identifying the ideal candidate. Limited data also suggests that YAG vitreolysis may lack efficacy in a significant proportion of patients.5
Article Sidebar
Ongoing research
Dr. Zhu said she is currently studying the impact of YAG vitreolysis on contrast sensitivity using a new technology for measuring contrast sensitivity. Traditionally, she said that contrast sensitivity checks are tedious and long, but she has a colleague who has automated the process to be done within minutes using AI and machine learning.
โIโm doing a couple of studies looking at patients with that machine before and after YAG vitreolysis treatment, and I think it might help elucidate which patients would benefit from treatment,โ she said.
About the physicians
Steve Charles, MD
Charles Retina Institute
Germantown, Tennessee
Christina Y. Weng, MD, MBA
Professor of Ophthalmology
Fellowship Program Director, Vitreoretinal Diseases & Surgery
Baylor College of Medicine
Houston, Texas
Dagny Zhu, MD
Medical Director and Partner
NVISION Eye Centers
Rowland Heights, California
References
- Webb BF, et al. Prevalence of vitreous floaters in a community sample of smartphone users. Int J Ophthalmol. 2013;6:402โ405.
- Wagle AM, et al. Utility values associated with vitreous floaters. Am J Ophthalmol. 2011;152:60โ65.
- Zhou I, et al. Outcomes of YAG laser vitreolysis in pseudophakic eyes with visually significant opacities following cataract surgery. Paper presented at the 2023 ASCRS Annual Meeting, May 5โ8, 2023, San Diego, California.
- Shah CP, Heier JS. YAG laser vitreolysis vs sham YAG vitreolysis for symptomatic vitreous floaters: a randomized clinical trial. JAMA Ophthalmol. 2017;135:918โ923.
- Nguyen JH, et al. Assessment of vitreous structure and visual function after neodymium: yttrium-aluminum-garnet laser vitreolysis. Ophthalmology. 2019;126:1517โ1526.
Relevant disclosures
Charles: Alcon
Weng: AbbVie, Alcon, Alimera Sciences, Apellis Pharmaceuticals, Boehringer Ingelheim, BVI, Carl Zeiss Meditec, EyePoint, Genentech, Iveric Bio, Novartis, Opthea, Regeneron, REGENXBIO, Springer Publishers
Zhu: None
Contact
Charles: scharles@att.net
Weng: Christina.Weng@bcm.edu
Zhu: dagny.zhu@gmail.com
